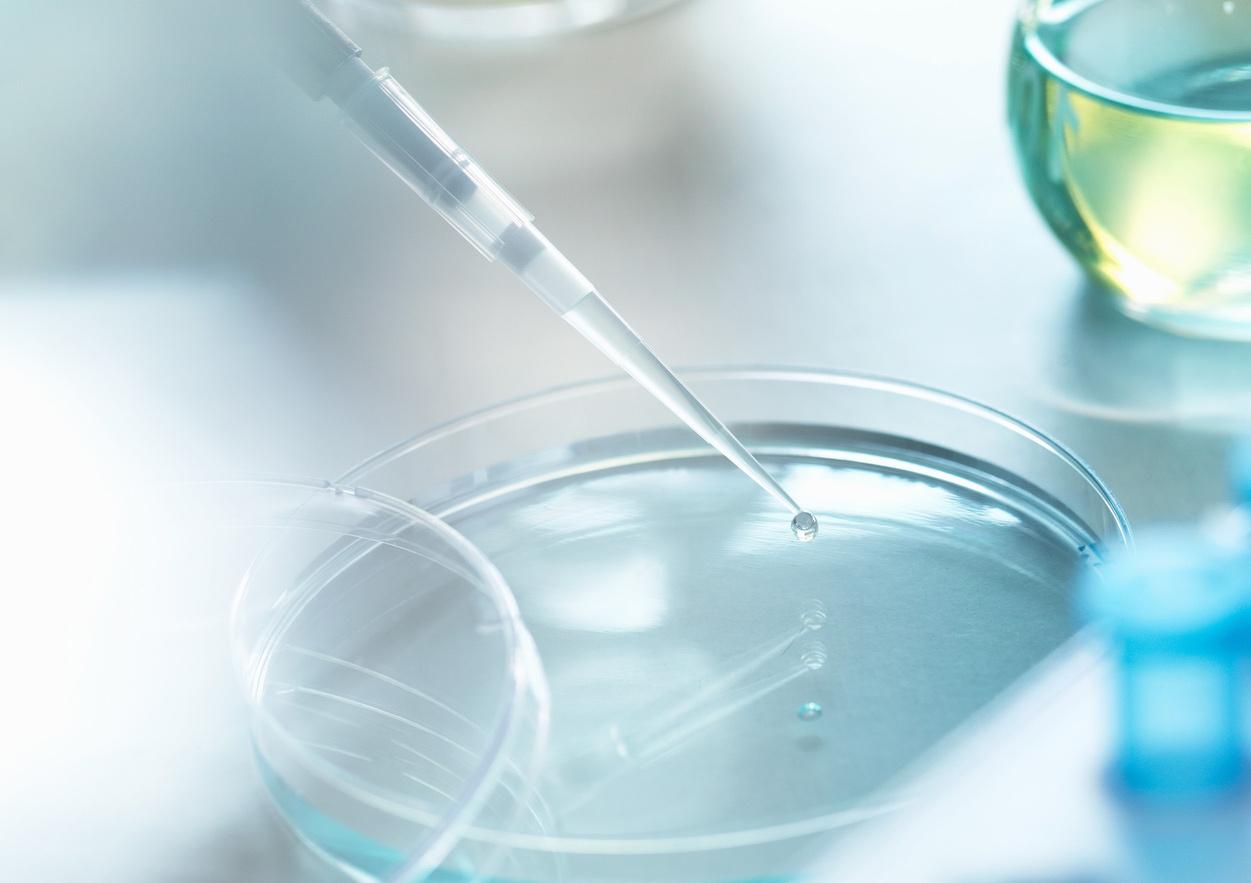

Das Wort "zinzino" bedeutet ein kleines Stück von großem Wert.
Für uns sind Sie von unschätzbarem Wert.
Deshalb ist es unsere Mission, das Beste aus jedem von uns herauszuholen. Unser gemeinsames Ziel, inspirieren wir zu Veränderungen.
Inspire Change in Life
Sie sind einzigartig.

Der Weg zu einer besseren Gesundheit ist individuell, kein Ratespiel.


Deine Reise beginnt mit unseren Gesundheitstests. So bringen wir Dich und die Welt wieder ins Gleichgewicht.
"Wir sind die Pioniere der testbasierten Nahrungsergänzung aus dem Land der Nordlichter, der Mitternachtssonne, der tiefsten Fjorde und der steilsten Berge."




Bring Licht ins Dunkle.
Schließe Dich dem neuen
Standard für persönliche Gesundheit an.
Führe den ersten Test als Ausgangsmessung durch, bevor Du Dein
individuelles Nahrungsergänzungsprogramm startest. Mit Hilfe des nachfolgenden Tests kannst Du Deine Fortschritte verfolgen und erhältst einen konkreten schriftlichen Beweis dafür, dass die Produkte etwas bewirken.
Unterstützt durch unseren wissenschaftlichen Beirat, und dem globalen Marktführer für Trockenbluttests.




Vitas ist ein unabhängig geführtes, GMP-zertifiziertes Auftragslabor für chemische Analysen mit Sitz in Oslo, Norwegen


unsere firmeninternen Spezialisten für Forschung und Entwicklung,
Eine ausgewählte Gruppe von angesehenen Ärzten, Wissenschaftlern, Forschern und führenden Gesundheitsexperten aus aller Welt.

Wissen ist Macht und innerer Frieden. Deine Reise zur Erkenntnis beginnt mit einem Tropfen Blut.

Wusstest Du, dass ein einziger Blutstropfen mehr Moleküle enthält als es Sandkörner in der Wüste Sahara gibt?
Unser Trockenbluttest liefert Dir konkrete Fakten über Deinen aktuellen Gesundheitszustand und die Nährstoffe, die Deinem Körper fehlen.


Wissenschaftlich geprüft. Von der Kraft der Natur inspiriert.
Testen, nicht raten.

Wir entschlüsseln das Geheimnis eines Lebens in Balance.

Unsere Formulierung ist eine wahre Kraft der Natur und Olivenöl ist der Schlüssel zum Erfolg.
Unser BalanceOil+ ist
öligem Fisch ähnlicher als Fischöl.
Durch die Kombination von reinem Fischöl mit nativem Olivenöl aus frühgeernteten Oliven bleiben die Omega-3Nährstoffe frisch und wirksam, mit denselben leistungsstarken Antioxidantien, die natürlich im Fisch vorkommen.

Unsere Gesundheitstests zeigen auf, welche Nährstoffe Dein Körper braucht.
Das Gesundheitsprotokoll erklärt Dir die weitere Vorgehensweise.

Hole Dir die für Dich lebenswichtigen Nährstoffe mit unseren drei maßgeschneiderten, in Synergie arbeitenden Nahrungsergänzungsmitteln.

Natürlich konzipierte Lösungen zur Nährstoffversorgung des gesamten Körpers. Von Innen und Aussen.
Unser Angebot für ganzheitliche Gesundheit und Wellness spielt in einer ganz eigenen Liga – von Nahrungsergänzungsmitteln bis hin zu biotechnologischen Hautnährstoffen.




Bringe Deinen
essenziellen
Omega-6:3-Spiegel ins Gleichgewicht.

UNSER MEISTVERKAUFTES NAHRUNGSERGÄNZUNGSMITTEL
FÜR DIE DARMGESUNDHEIT
Regeneriere Deine Darmgesundheit.
Unterstütze Deine erste Abwehrlinie.































